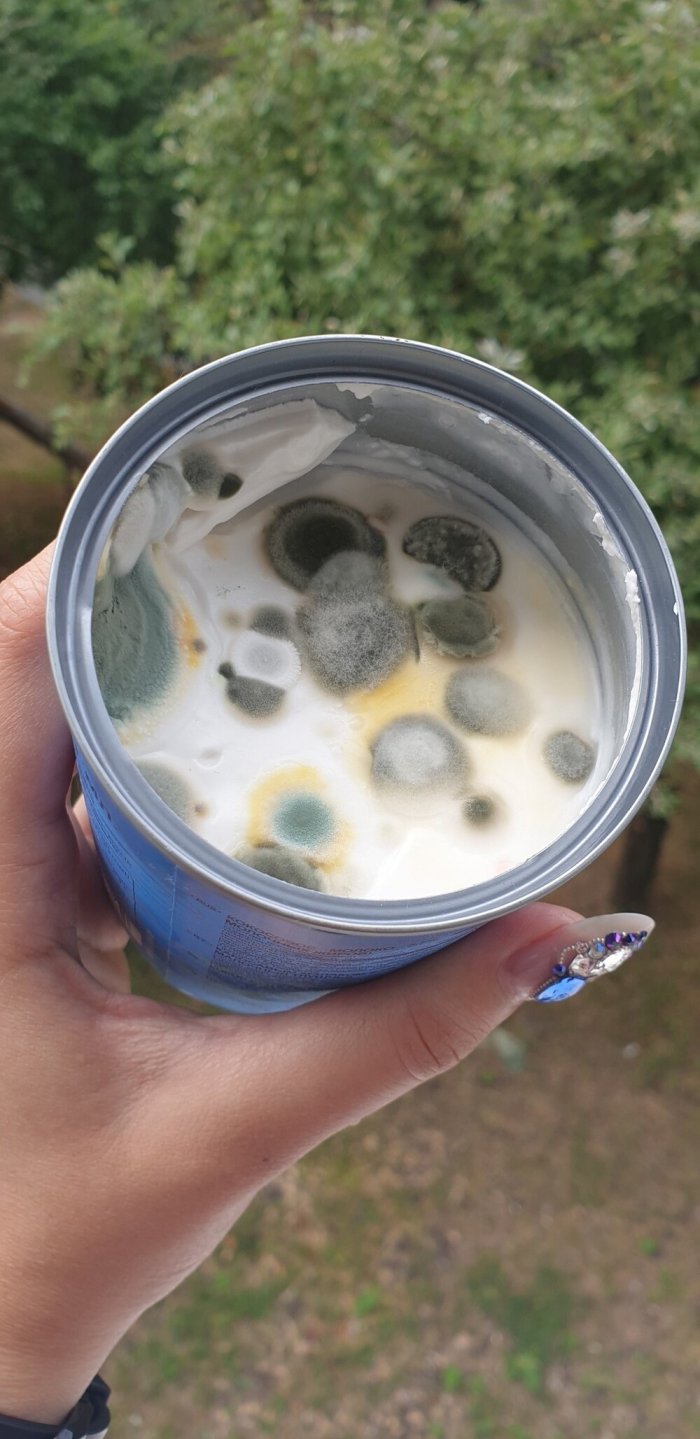
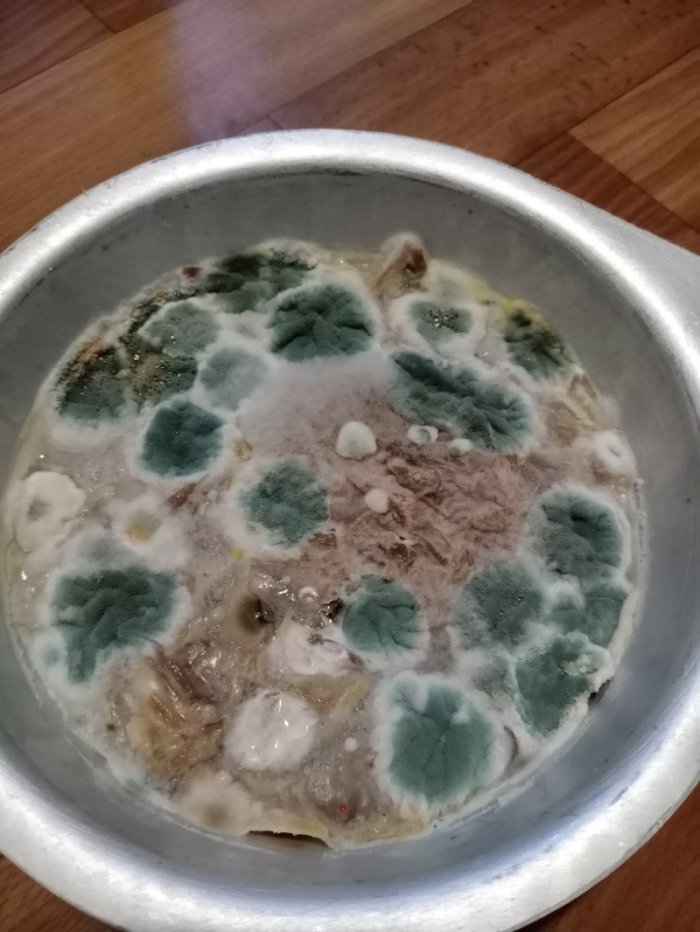

Что происходит с забытыми продуктами (14 фото)
![]() |
Хорошее настроение. Фото и видео приколы и всё это на нашем портале, наши журналисты стараються для вас, чтоб поднять вам настроение в щитанные секунды. Все фото и видео приколы и новинки сети интернет находятся здесь на нашем портале. Хоршего вам настроения... |
Пользователи интернета постановили показать, что происходит с провиантами питания, если невзначай забыть их на несколько дней или даже недель. В таковом случае, в девало вступают неодинаковые грибки, успешно перерабатывая недоеденное. Ну а временами, все это выглядит будет необычно, и получается занимательная композиция. Взираем.

Похожие новости дня сегодня
( 0 ) Комментарии